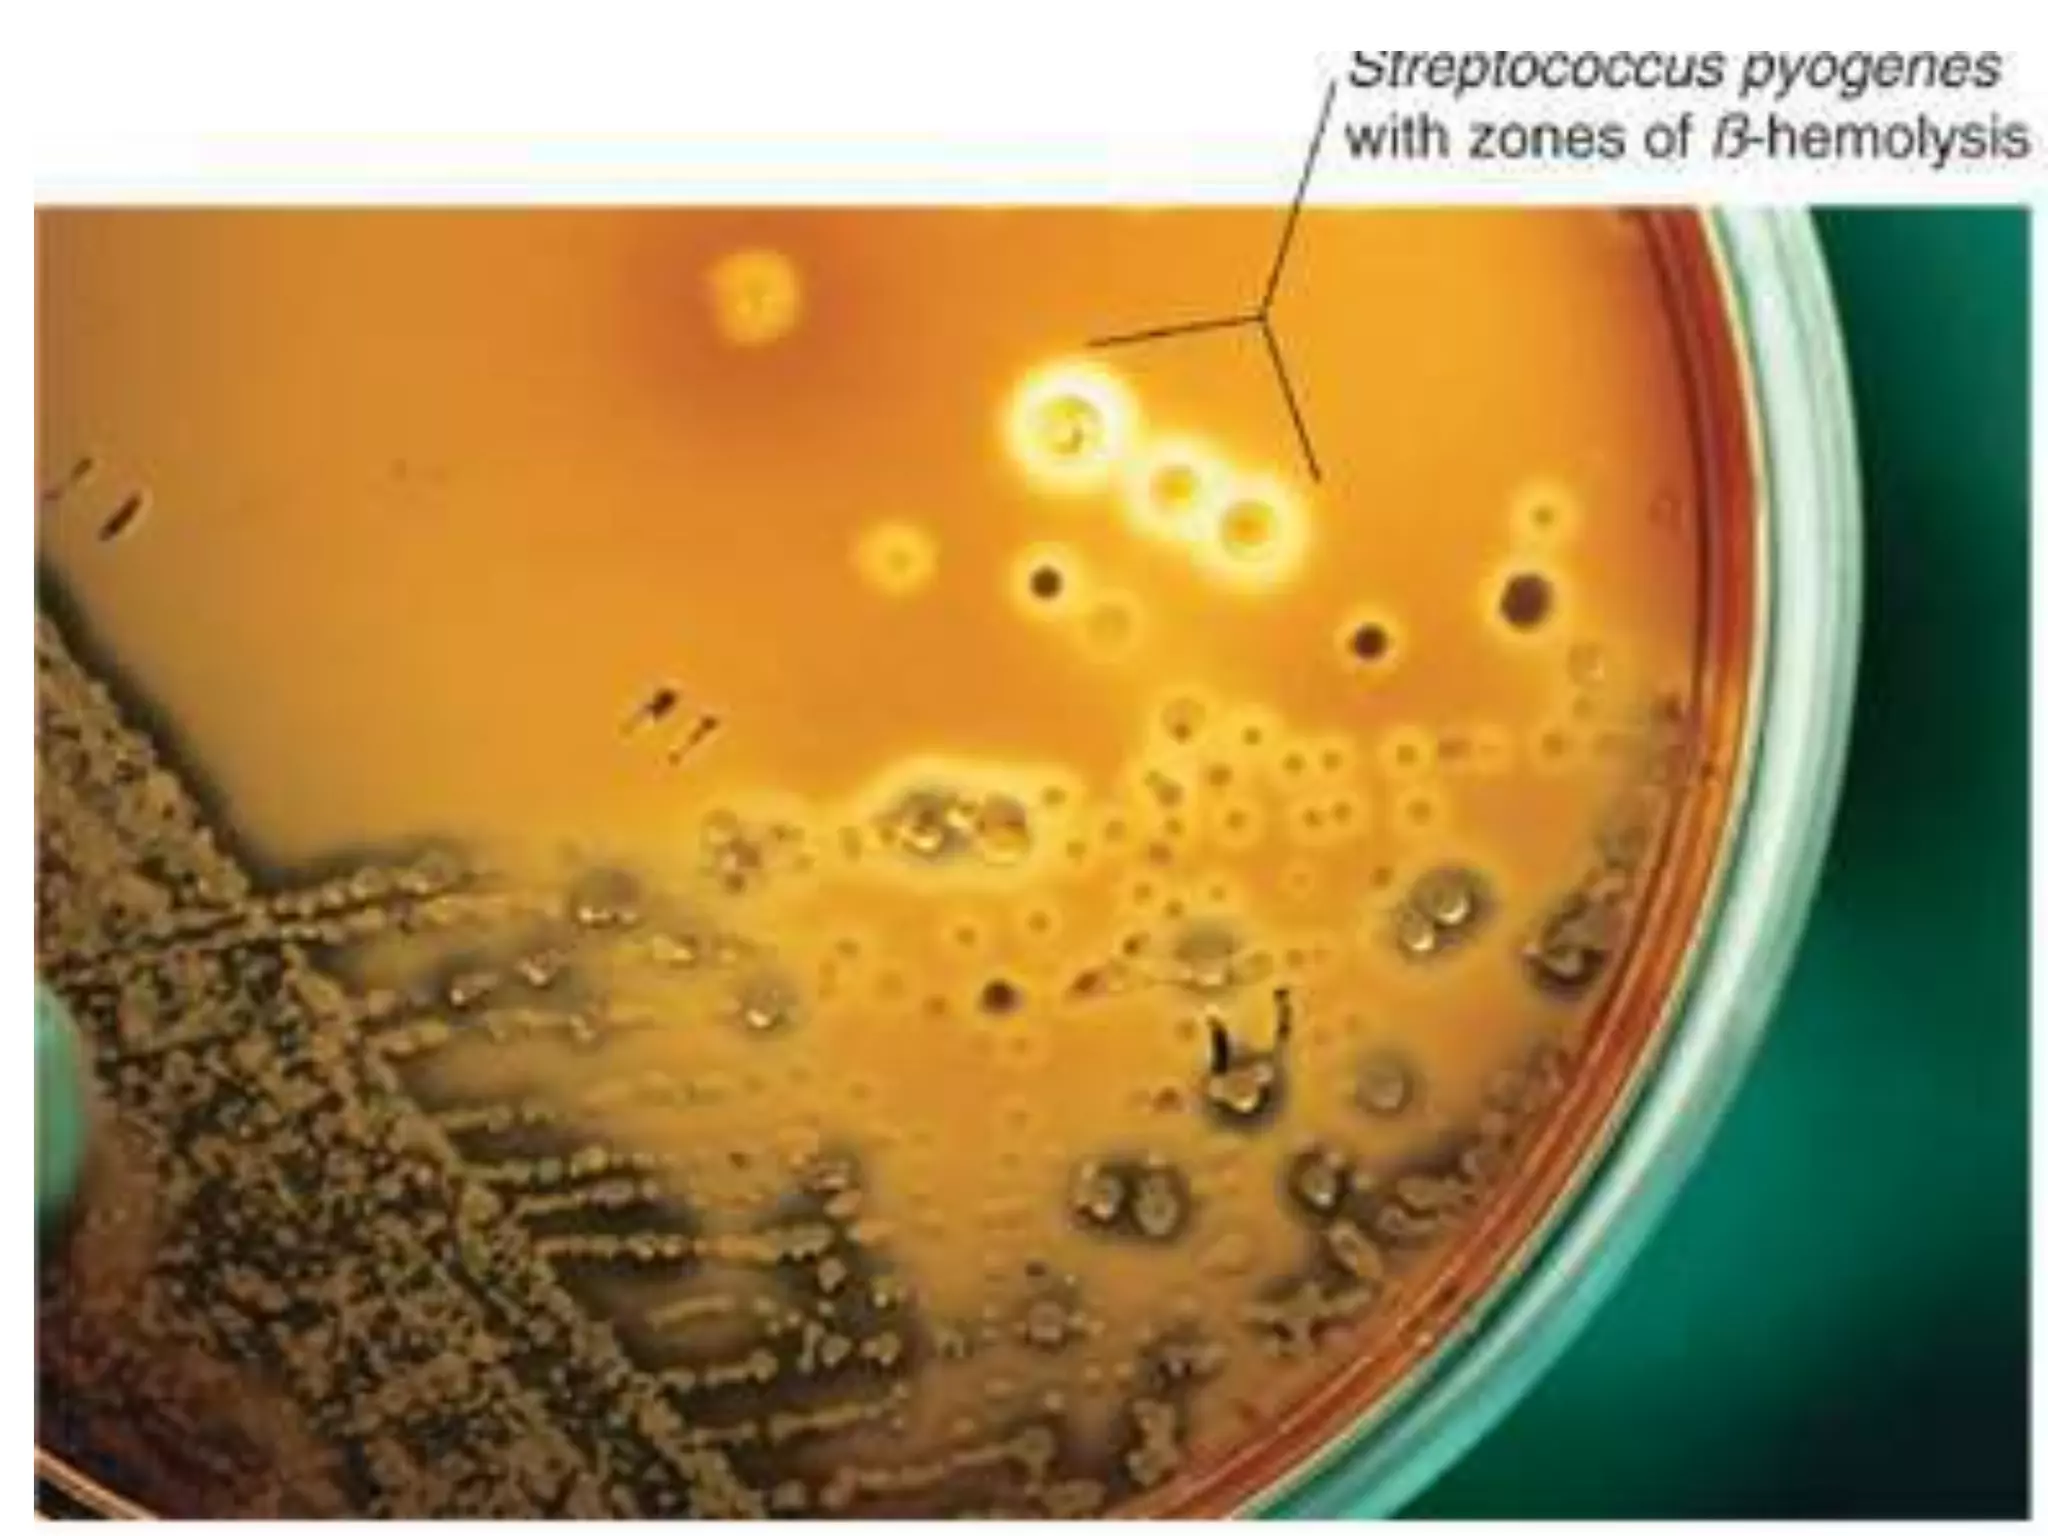
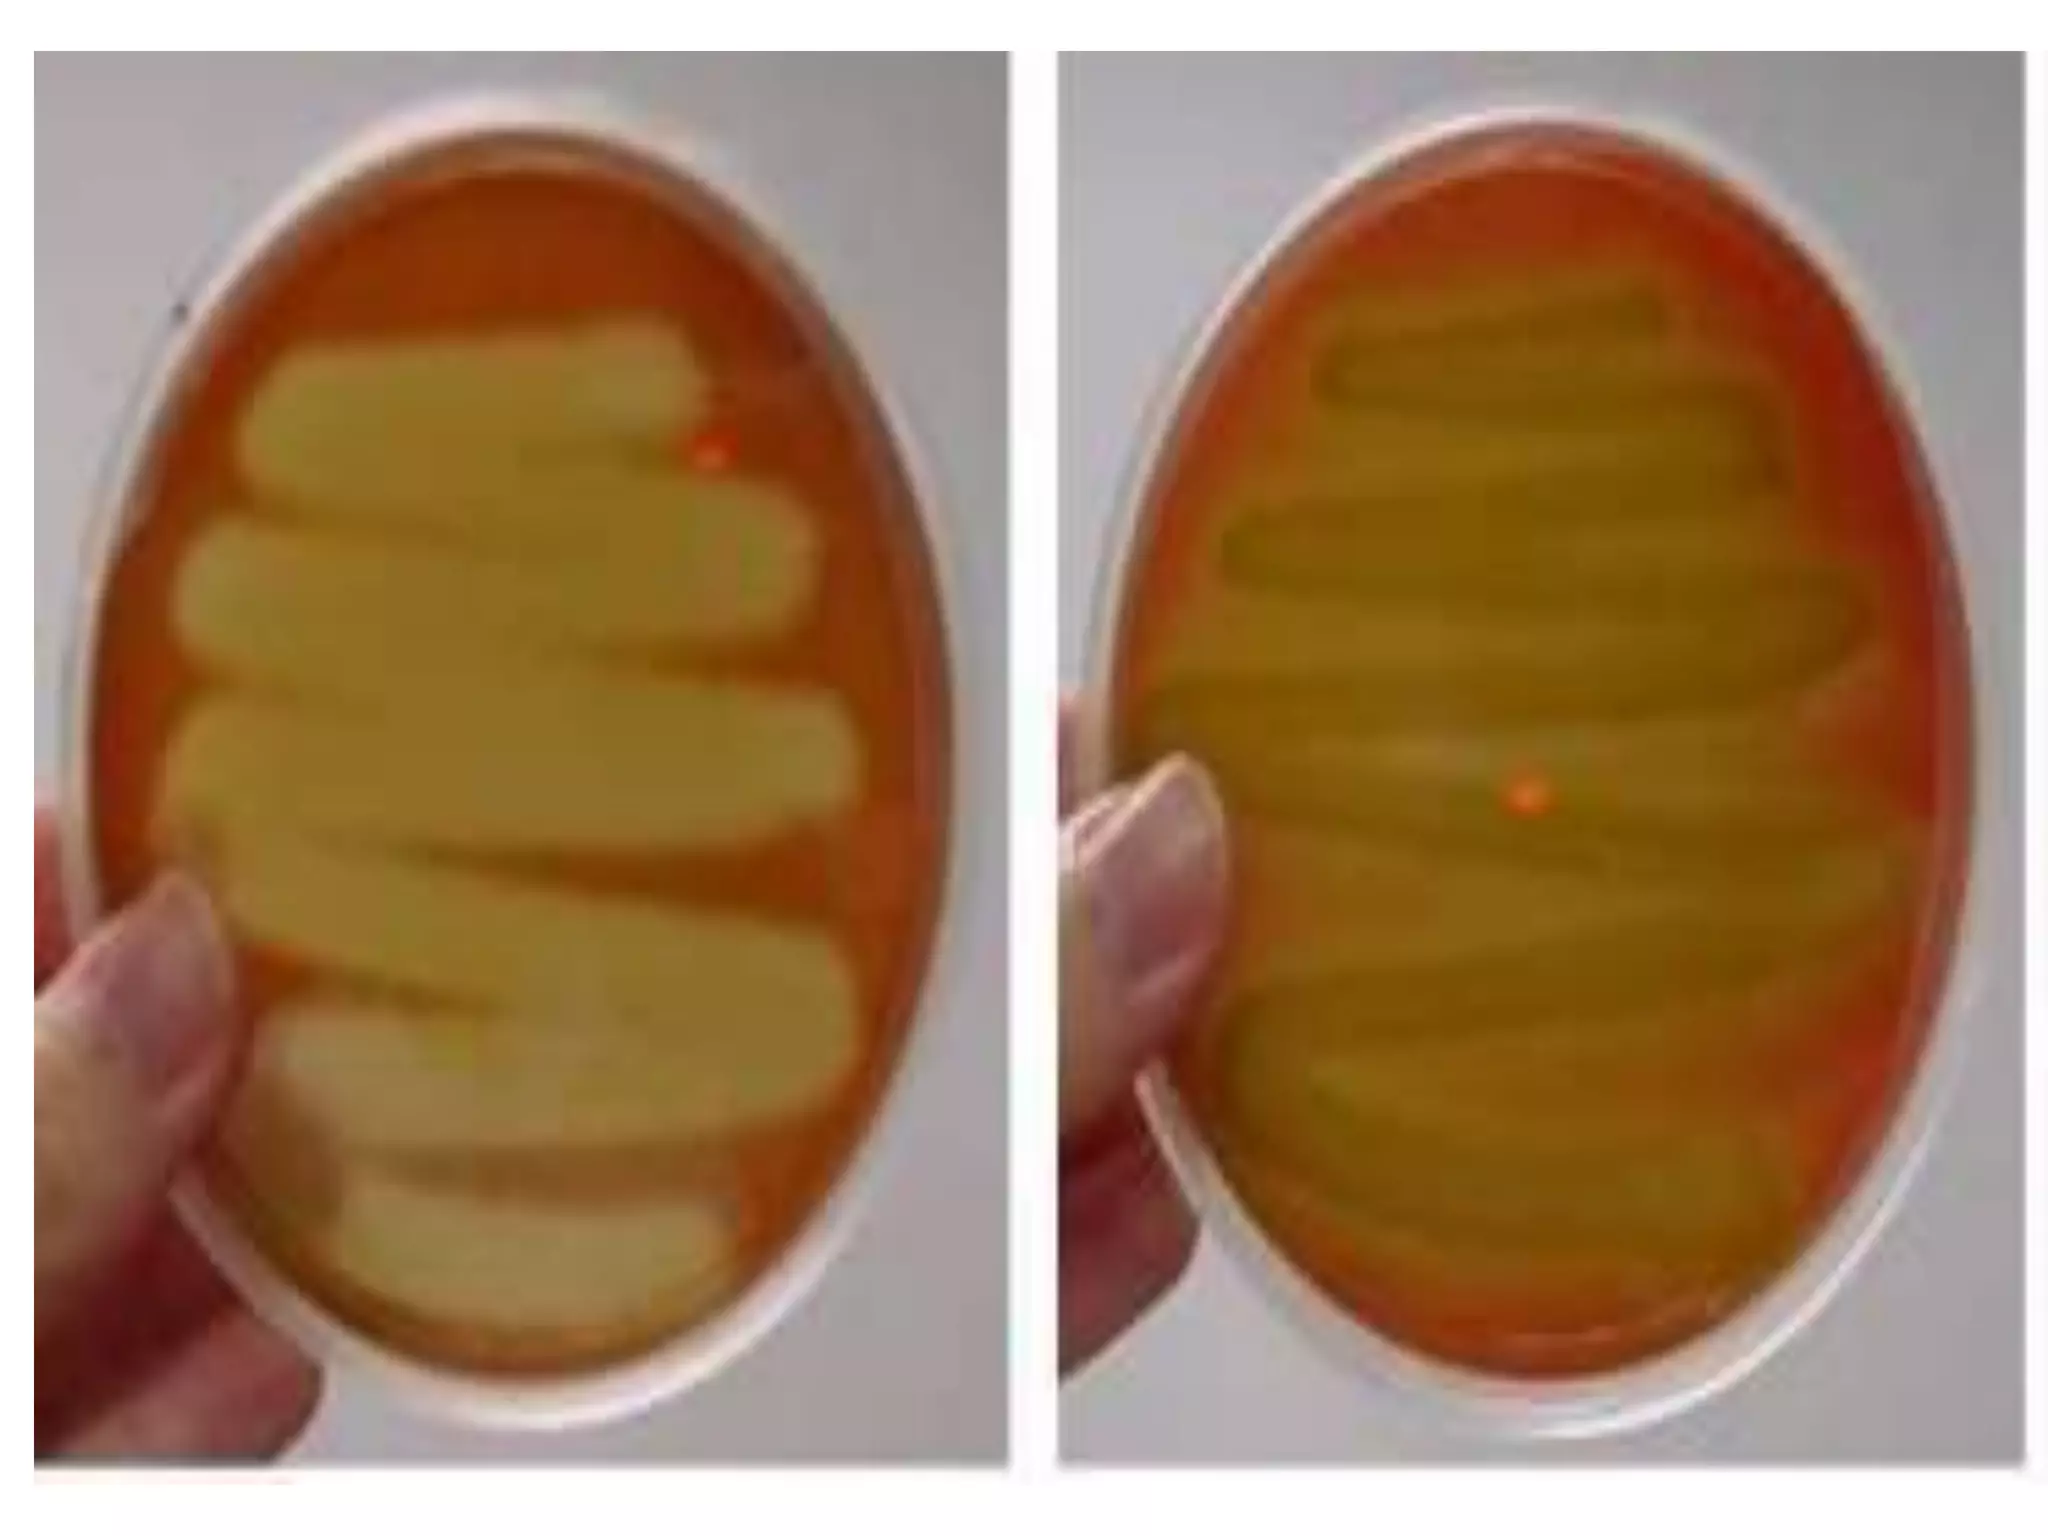
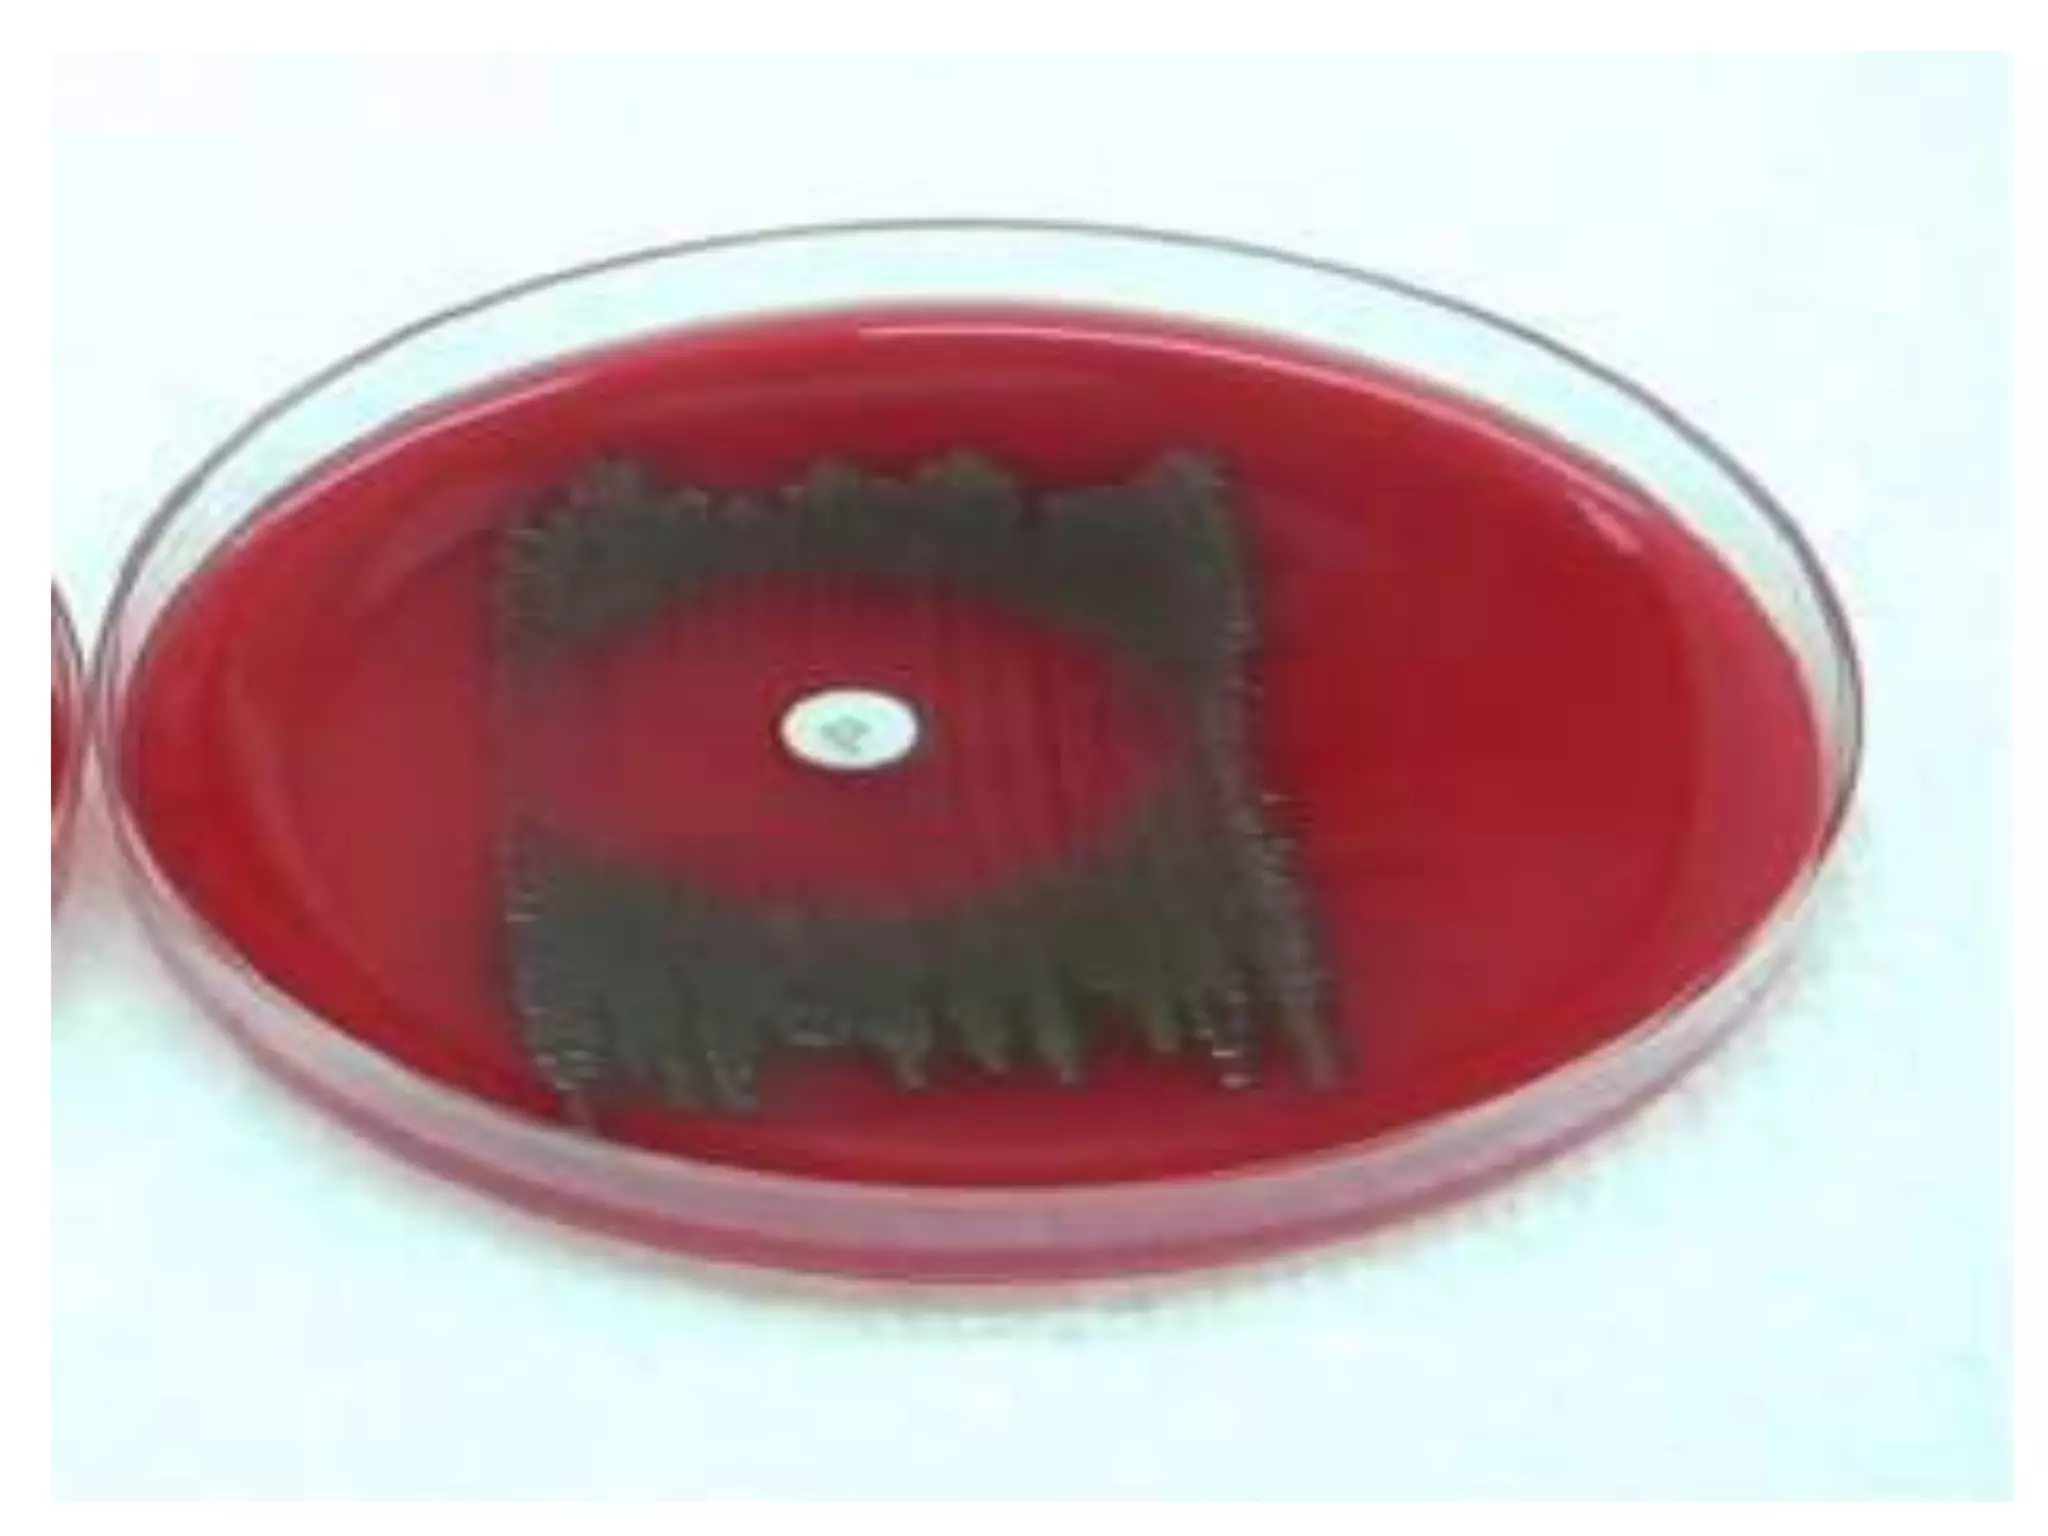

This document summarizes key information about various Streptococcus bacteria. It describes their morphology, cultural characteristics, biochemical properties, pathogenic species and diseases caused. Streptococcus pyogenes, pneumoniae, viridans and faecalis are discussed in detail, outlining their laboratory diagnosis and treatment. Classification systems for streptococci include Lancefield grouping and hemolytic reactions on blood agar. Streptococcus pyogenes produces various virulence factors and causes impetigo, pharyngitis, and rheumatic fever. Pneumoniae commonly colonizes the nasopharynx and can lead to pneumonia or otitis media.